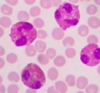

Defina las caracteristicas del Tejido Sanguineo
Es un Tejido Conectivo Especializado Fluido (Circulante)
Posee estructuras formes y plasma.
Cuáles son las estrucutras formes del Tejido Sanguineo?
Eritrocitos (Globulos Rojos)
Leucocitos (Globulos Brancos)
Trombocitos (Plaquetas)
Defina las características del plasma del Tejido Sanguineo.
90% es água
Posee:
Proteínas (Albumina, Fibrinogeno y Globulina)
Eletrolitos
Gases (Co2 y o2)
Sustancias reguladoras
Como se observa la sangre?
A través de extendidos sanguineos que son placas de vidrio que utilizamos para mirar en microscopio.
O hematocrito que indica la proporción de glóbulos rojos en la sangre en relación con el volumen total de la sangre.
Cuál es la porcentaje de eritrocitos en la sangre de hombres y mujeres?
Mujeres: 35 a 45%
Hombres: 40 a 50%
Características de los eritrócitos.

Células anucleadas y sin organelas.
Es un disco biconcavo.
Respiran y producen ATP a través de glucolisis.
Tiene una vida media de 120 dias.
Tienen la capacidad de adaptarse al los distintos diametros de los vasos.
Tienen elasticidad y flexibilidad.
Por qué la hipoglucemia es peligrosa?
Porque así como los eritrocitos, el cerebro también utiliza la glicosis para producir energia.
Por qué los eritrocitos son biconcavos?
Su forma biconcava aumenta la superficie y permite transportar más oxígeno y dióxido de carbono
Como es la entrega de oxígeno de los eritrocitos a los tejidos?
Por difusión
Cuál es la función de los eritrocitos?
Transporte de gases (llevar o2 a los tejidos)
Cual és la tinción de los eritrocitos? Y porque?
Es acidofila por la cantidad de hemoglobinas (que son proteínas)
Cuál es el sistema de degradación de los eritrocitos?
Sistema fagocitico mononuclear: Los macrofagos del bazo degradan los eretrocitos.
Cuál es la principal función del bazo en el sistema sanguineo?
Hacer hemocateresis - reciclar las células. Una lisis fisiologica
Qué es hemolisis?
Una lisis patológica de las celulas de la sangre
Cuál es son las principales estructuras que permiten la flexibilidad y determinan la forma de los eretrocitos?
Las proteínas Espectrina, Banda 3 y Glucoforina C
Que se encuentra en la superficie de las proteínas de los eritrocitos?
Azúcar - el grupo sanguíneo
El grupo del Sistema ABO es un conjunto de azúcares - olisacarideos
Donde se encuentra el fator RH?
Exclusivamente en los eritrocitos.
Como funcionan las inmunoglobulinas?
Los anticuerpos reconocen antígenos y los marcam para serem muertos.
Se adheren en aquello que no reconocen, como por ejemplo bactérias.
Ellos hacen una opsonización (marcam las bactérias para serem atacadas y morir)
Como funciona el sistema ABO?
Los eritrocitos tienen un antigeno y un anticuerpo.
ej. Antigeno A, anticuerpo B
Función y caracteristicas de la Hemoglobina.
Función de transporte de o2.
Es una proteína contenida dentro de los eritrocitos que se une al oxígeno.
Constituida por 2 partes:
Grupo prostetico Hemo
Parte proteíca Globina
Qué significa Grupo prostetico?
Un grupo prostético es una parte no proteica de una molécula de proteína que es esencial para su función. .
Significa que la unión con la globina es obigatório y que no se puede separarlas sin que las destruya y no es reutilizable.
Características del grupo Hemo.
Es un grupo prostético.
Posee una unión fuerte con la globina.(covalente)
Posee un atomo de Fe2+ (Hierro), siempre con 2+ que es el estado ferroso.
Es derivado de la porfina.
Cuando degradado forma bilirrubina
Cuál estado del hierro es necesário para el transporte de o2?
Fe2+ (hierro), siempre con 2+ que es el estado ferroso.
El ferro en el estado ferrico, Fe+3 no sirve para transportar o2.
Características del grupo Globina.
Es la parte proteica.
Es heterocatenaria - una estructura con 4 cadenas diferentes entre si
Posee 4 subunidades: 2 alfa y 2 beta
Y cada subunidade contiene 4 hemos, o sea 4 hierros en estado ferroso.
Por tanto cada hemoglobina puede transportar 4 moleculas de 02.